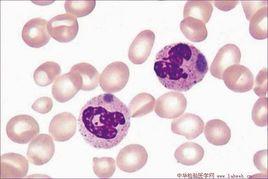
杜勒小體

Dohle小體常見於嚴重的感染,如肺炎、敗血症和燒傷等。
相關詞條
-
葉尼塞河
。 葉尼塞河 有2條源流,一是大葉尼塞河,一是小葉尼塞河。 兩河於克孜勒...。水系組成 葉尼塞河 葉尼塞河幹流從克孜勒至奧茲納琴諾耶為上葉尼塞河,長約...洪戈爾省交界之處的杭愛山脈東北坡,河流向西北流,沿途接納圖勒河、恰拉河...
簡介 水系組成 流域 自然特徵 相關河流 -
狗
簡介概念狗狗,通常指家犬,也稱犬,一種常見的犬科哺乳動物,是狼的近親。可以幫主人守門,被一些人稱為“人類最忠實的朋友”,也是飼養...
簡介 馴化 演化 功能 壽命 -
遺傳性黏多糖貯積症
病症概念1.黏多糖貯積症Ⅰ型患者病變呈進行性發展,常於15歲左右因心臟病變及呼吸道反覆感染而死亡。因環樞半脫位,而壓迫背髓或背膜...
病症概念 症狀體徵 疾病病因 病理生理 診斷檢查 -
黏多糖貯積症Ⅰ型
貯積症Ⅰ型本型又稱胡勒(Hurler)綜合徵、承霤病、MPSI-H。既往曾稱脂肪軟骨營養不良、軟骨-骨營養不良。胡勒(Hurler)於1917年...染色體隱性遺傳。其基本缺陷是溶酶體a-L-艾杜糖醛酸酶缺乏基因定位在22...
概述 流行病學 病因 發病機制 臨床表現 -
路易斯·巴斯德
,他發現,發酵液里有一種比酵母菌小得多的球狀小體,它長大後就是酵母菌。過了不久,在菌體上長出芽體,芽體長大後脫落,又成為新的球狀小體,在這...’É;cole centrale)的創辦人之一杜瑪...
生平 成果 人物故事 評價 紀念 -
淋巴結腫
病因感染引起由急性感染、細菌病毒立克次體等引起如急性蜂窩織炎上呼吸道感染傳染性單核細胞增多症恙蟲病等。由慢性感染、細菌真菌蠕蟲衣...
病因 機理 診斷 鑑別診斷 預防 -
實用臨床微生物學檢驗與圖譜
諾卡菌屬第九節 紅球菌屬第十節 鏈黴菌屬與馬杜拉放線菌屬第十一節 庫特菌...桿菌屬第十七節 布拉格菌屬第十八節 萊克勒菌屬第十九節 光桿菌屬第二十節...七節 特布爾西菌屬第二十八節 致病桿菌屬第二十九節 默勒菌屬第三十節 勒...
媒體推薦 內容簡介 作者簡介 目錄 -
安徽省葉集試驗區
百餘畝,後因戰亂,遂遭破壞。清道光年間,本地支、孟、杜三大家族曾集資...
葉集地理位置 概況 行政區劃 歷史沿革 地理氣候